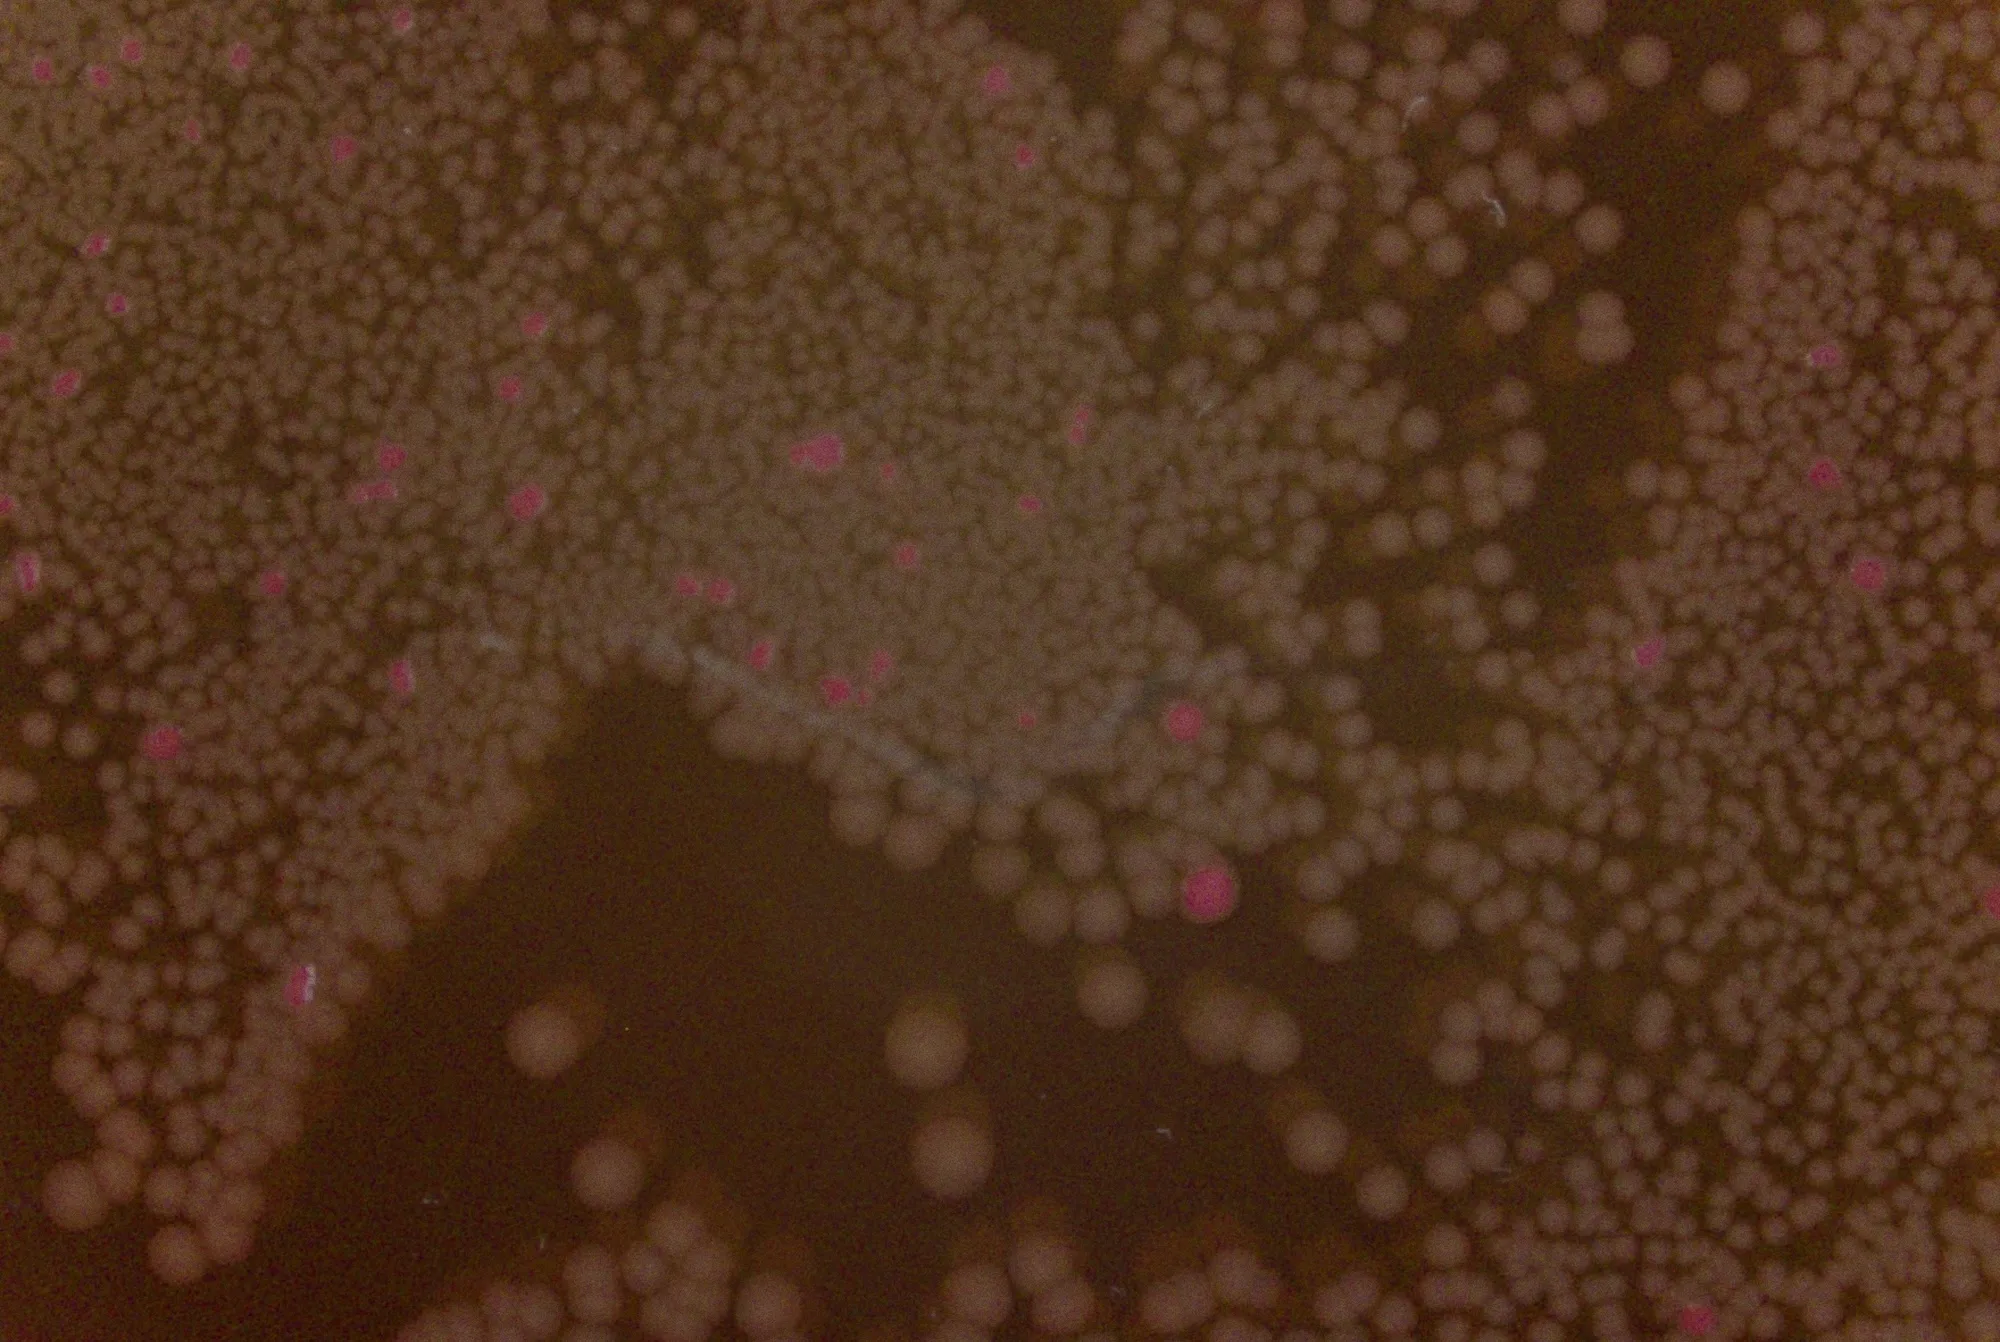

Automate your food & water QC testing with ISO validated AI-models
Go from manual to automated QC workflows with AI models trained on 50M+ microbiological experiments and built for ISO methods.
Methods
We support all plate-based methods. Here's a selection of the most common ones.
FAQ
Get answers to commonly asked questions.
Are we 17025 compliant?
Great question, let’s tell you how we interpret this concern!
You are asking: Do you operate under a quality system that ensures technically valid, traceable, and reliable test results according to ISO 17025?
To that, the short answer: ISO/IEC 17025 accreditation applies to laboratories, not instruments. Reshape supports compliant implementation within an ISO 17025 framework.
Slightly longer explanation:
- Accreditation bodies accredit laboratories, not equipment or vendors.
- Reshape does not change the validated ISO reference method (e.g., ISO 4833-1).
- The platform automates execution steps (e.g., imaging, counting, documentation) while maintaining:
- Traceability
- Controlled documentation
- Audit readiness
- Technical record integrity
A compliant implementation typically includes:
- Defined intended use and requirements (URS)
- Risk assessment
- Equipment qualification (IQ/OQ)
- Method verification (PQ)SOP updates
- Training documentation
- Ongoing monitoring
When implemented in this structured way, automation is fully aligned with ISO/IEC 17025 requirements.
Is our platform validated?
Validation primarily applies to analytical methods - not to automation systems. We don't change thet validated analytical method.
Explanation:
There is an important distinction under ISO 17025:
- Validation → applies to methods
- Verification → applies to method performance within a specific laboratory
- Qualification → applies to equipment/systems
Reshape does not redefine or replace validated ISO reference methods. Those methods are already validated at the standard level.
Instead, Reshape:
- Is qualified during installation (IQ/OQ)
- Is subject to performance qualification (PQ) / method verification in each laboratory
- Provides documented performance data to support equivalence
So the more accurate framing is: The analytical method remains validated; the automated workflow is qualified and verified within the laboratory.
Fun fact: We are actually on the global ISO committee helping to improve methods and standards for better health and safety.
Do we need to validate your technology?
You do not need to re-validate the ISO reference method. You do need to verify performance in your laboratory as required by ISO 17025, with or without Reshape.
Explanation:
Since Reshape does not change
- Media preparation
- Incubation conditions
- Colony definitions
- Sampling/dilution principles
- Reporting logic defined by the ISO method
There is no need to re-validate the analytical method itself.
However, ISO 17025 requires laboratories to:
- Verify that the method performs as expected under their specific conditions
- Document equivalence (typically via PQ)
This typically includes:
- Accuracy comparison vs. existing workflow
- Precision testing
- Defined acceptance criteria
- Technical manager sign-off
This requirement applies regardless of whether counting is manual or automated.
Would adopting your technology disrupt our workflow?
No. Reshape does not change the validated ISO reference method. It automates specific workflow steps (e.g., imaging and counting) in a controlled, documented manner aligned with ISO 17025. Implementation includes qualification, verification, SOP updates, and training to ensure continuity and compliance without disrupting core laboratory processes.
Practical impact:
Rather than disrupting workflow, automation typically:
- Increases consistency of execution
- Strengthens traceability
- Reduces manual variability
- Improves documentation and audit readiness
The laboratory workflow evolves, but it remains aligned with ISO reference methods and ISO 17025 expectations.We always suggest reaching out to our technical team so you can have a full discussion on how Reshape could support your workflows: (AE / sales / Diogo email / book-a-demo?)
Is this solution compatible with our IT and data processing requirements?
Yes—the Reshape platform is SOC2 type 2 and ISO27001 certified and compliant with enterprise IT requirements. The platform is already implemented globally across large enterprises, including pharmaceutical companies.
We provide extensive documentation on our information security compliance, and a typical implementation will include a review by IT to ensure compliance and align on implementation and configuration plans.
ISO 17025-Compliant Microbiology Automation
If you're interested in a more extensive understanding of this topic, please read the write-up on the entire process.














